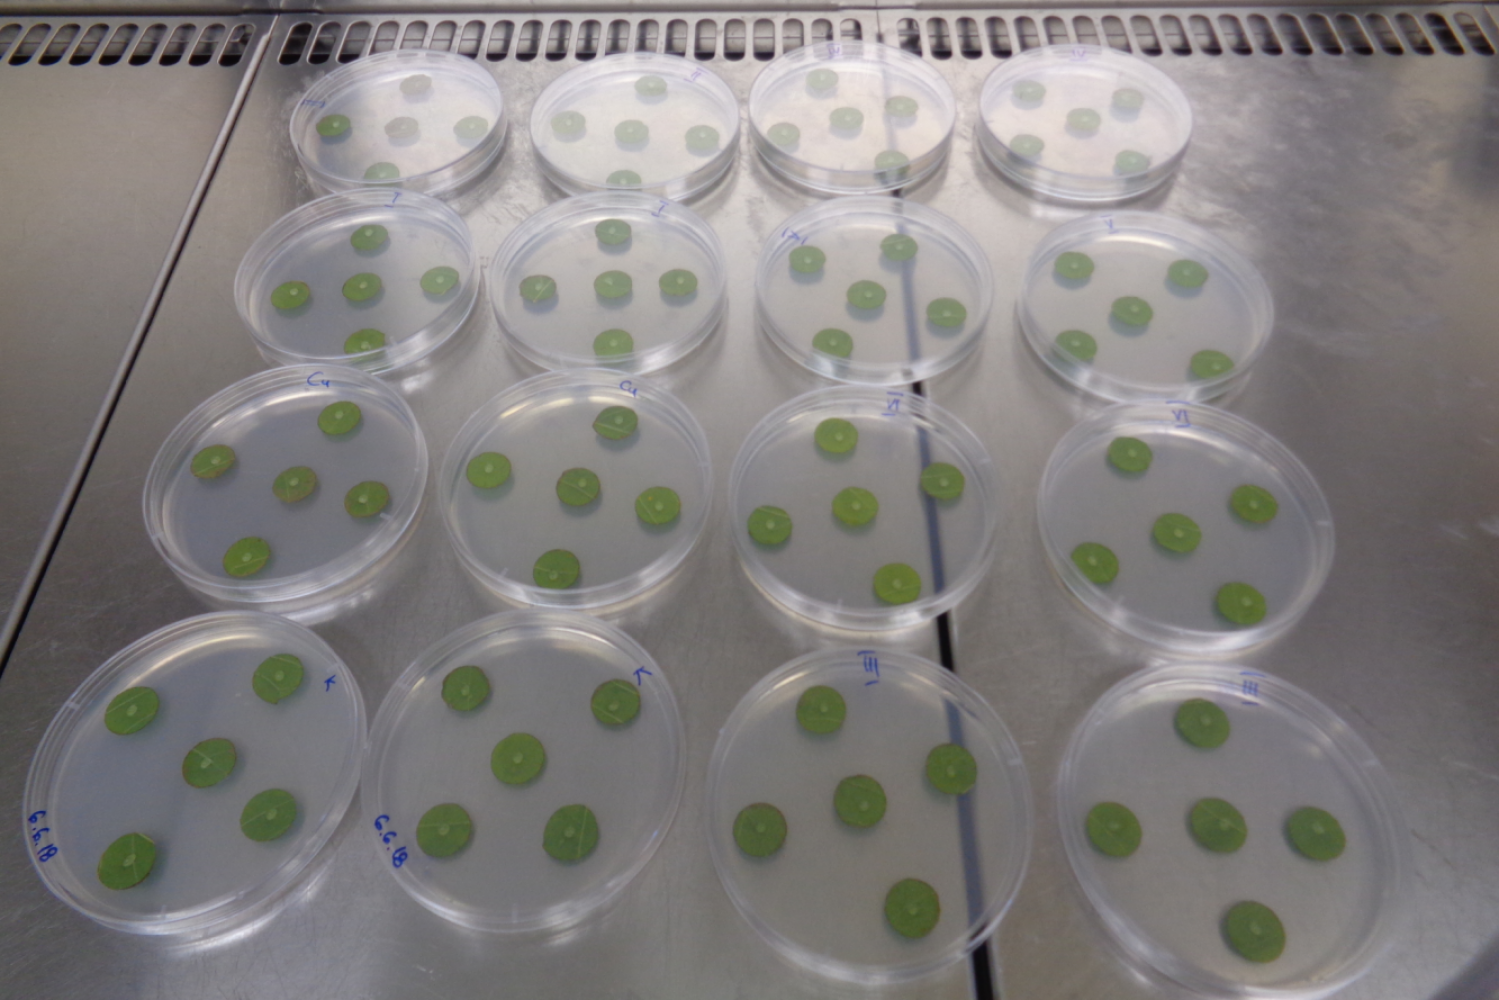
Univerzitet Crne Gore

Important Statement
Compliance status
We firmly believe that the internet should be available and
accessible to anyone and are committed to
providing
a website that is accessible to the broadest possible audience, regardless of ability.
To fulfill this, we aim to adhere as strictly as possible to
the World Wide Web Consortium’s (W3C) Web
Content
Accessibility Guidelines 2.1 (WCAG 2.1) at the AA level. These guidelines explain how to
make web content
accessible to people with a wide array of disabilities. Complying with those guidelines
helps us ensure that
the
website is accessible to blind people, people with motor impairments, visual impairment,
cognitive
disabilities,
and more.
This website utilizes various technologies that are
meant to make it as accessible as possible at all times.
We
utilize an accessibility interface that allows persons with specific disabilities to
adjust the website’s UI
(user interface) and design it to their personal needs.
Additionally, the website utilizes an AI-based application
that runs in the background and optimizes its
accessibility level constantly. This application remediates the website’s HTML, adapts its
functionality and
behavior for screen-readers used by blind users, and for keyboard functions used by
individuals with motor
impairments.
If you wish to contact the website’s owner please use the
website's form
Screen-reader and keyboard
navigation
Our website implements the ARIA attributes
(Accessible Rich Internet Applications) technique, alongside
various
behavioral changes, to ensure blind users visiting with screen-readers can read,
comprehend, and enjoy the
website’s functions. As soon as a user with a screen-reader enters your site, they
immediately receive a
prompt
to enter the Screen-Reader Profile so they can browse and operate your site effectively.
Here’s how our
website
covers some of the most important screen-reader requirements:
- Screen-reader
optimization:
we run a process that learns the
website’s components from top to bottom, to ensure ongoing compliance even when
updating the website. In
this
process, we provide screen-readers with meaningful data using the ARIA set of
attributes. For example, we
provide accurate form labels; descriptions for actionable icons (social media
icons, search icons, cart
icons,
etc.); validation guidance for form inputs; element roles such as buttons,
menus, modal dialogues (popups),
and others.
Additionally, the background process scans all of the
website’s images. It provides
an accurate and meaningful image-object-recognition-based description as an ALT
(alternate text) tag for
images that are not described. It will also extract texts embedded within the
image using an OCR (optical
character recognition) technology. To turn on screen-reader adjustments at any
time, users need only to
press
the Alt+1 keyboard combination. Screen-reader users also get automatic
announcements to turn the
Screen-reader
mode on as soon as they enter the website.
These adjustments are
compatible with popular screen
readers
such as JAWS, NVDA, VoiceOver, and TalkBack.
- Keyboard navigation
optimization: The background process also
adjusts the website’s HTML and adds various behaviors using JavaScript code to make
the website operable by
the keyboard. This includes the ability to navigate the website using the Tab and
Shift+Tab keys, operate
dropdowns with the arrow keys, close them with Esc, trigger buttons and links using
the Enter key, navigate
between radio and checkbox elements using the arrow keys, and fill them in with the
Spacebar or Enter
key.
Additionally, keyboard users will find
content-skip menus available at any time by clicking
Alt+2,
or as the first element of the site while navigating with the keyboard. The
background process also handles
triggered popups by moving the keyboard focus towards them as soon as they appear,
not allowing the focus to
drift outside.
Users can also use
shortcuts such as “M” (menus), “H” (headings), “F” (forms), “B”
(buttons), and “G” (graphics) to jump to specific elements.
Disability profiles supported on our
website
- Epilepsy Safe
Profile:
this profile enables people with epilepsy to
safely use the website by eliminating the risk of seizures resulting from
flashing or blinking animations
and
risky color combinations.
- Vision Impaired
Profile:
this profile adjusts the website so that it
is
accessible to the majority of visual impairments such as Degrading Eyesight,
Tunnel Vision, Cataract,
Glaucoma, and others.
- Cognitive Disability
Profile:
this profile provides various
assistive
features to help users with cognitive disabilities such as Autism, Dyslexia,
CVA, and others, to focus on
the
essential elements more easily.
- ADHD Friendly
Profile
this profile significantly reduces
distractions
and noise to help people with ADHD, and Neurodevelopmental disorders browse,
read, and focus on the
essential
elements more easily.
- Blind Users Profile
(Screen-readers):
this profile adjusts the website
to be compatible with screen-readers such as JAWS, NVDA, VoiceOver, and
TalkBack. A screen-reader is
installed
on the blind user’s computer, and this site is compatible with it.
- Keyboard Navigation
Profile (Motor-Impaired):
this profile enables
motor-impaired persons to operate the website using the keyboard Tab, Shift+Tab,
and the Enter keys. Users
can
also use shortcuts such as “M” (menus), “H” (headings), “F” (forms), “B”
(buttons), and “G” (graphics) to
jump
to specific elements.
Additional UI, design, and readability
adjustments
- Font
adjustments – users can increase
and decrease its size, change its family (type), adjust the
spacing, alignment, line height, and more.
- Color
adjustments – users can select
various color contrast profiles such as light, dark, inverted, and
monochrome.
Additionally, users can swap color schemes of titles, texts, and backgrounds
with over seven different
coloring options.
- Animations
–
epileptic users can stop
all
running animations with the click of a button. Animations controlled by the
interface include videos, GIFs,
and CSS flashing transitions.
- Content highlighting – users can choose to emphasize essential elements such as links and
titles. They can also
choose
to highlight focused or hovered elements only.
- Audio
muting – users with hearing
devices may experience headaches or other issues due to automatic audio
playing. This option lets users mute the entire website instantly.
- Cognitive disorders – we utilize a search engine linked to Wikipedia and Wiktionary,
allowing people with cognitive
disorders to decipher meanings of phrases, initials, slang, and others.
- Additional
functions
we allow users to change cursor color
and size, use a
printing mode, enable a virtual keyboard, and many other functions.
Assistive technology and browser
compatibility
We aim to support as many browsers and assistive
technologies as possible, so our users can choose the best
fitting tools for them, with as few limitations as possible. Therefore, we have worked
very hard to be able to
support all major systems that comprise over 95% of the user market share, including
Google Chrome, Mozilla
Firefox, Apple Safari, Opera and Microsoft Edge, JAWS, and NVDA (screen readers), both for
Windows and MAC
users.
Notes, comments, and
feedback
Despite our very best efforts to allow anybody to adjust the
website to their needs, there may still be pages
or sections that are not fully accessible, are in the process of becoming accessible, or
are lacking an
adequate
technological solution to make them accessible. Still, we are continually improving our
accessibility, adding,
updating, improving its options and features, and developing and adopting new
technologies. All this is meant
to
reach the optimal level of accessibility following technological advancements. If you wish
to contact the
website’s owner, please use the website's form